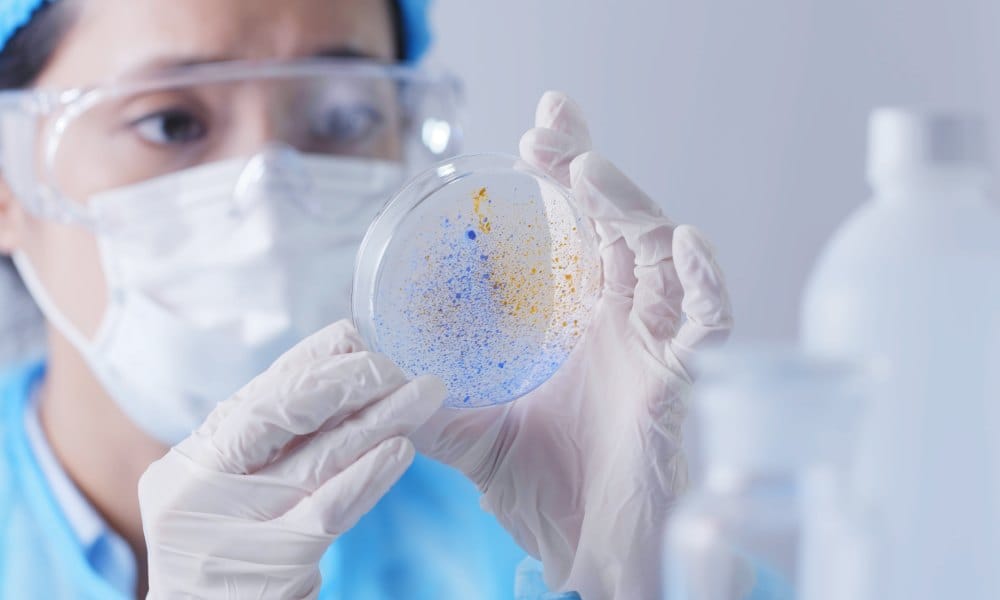
A medical laboratory professional wearing a face mask and gloves as they hold a petri dish with a cell culture.

Professional Development

Education
Bridging the Readiness Gap: How Conversational AI and Virtual Simulation Are Transforming Nursing Education
The Licensure-Competency Chasm Nursing has evolved throughout the decades to keep up with the changes driven by technology and now ...

Education
Financial Pressures Facing Academic Medical Centers Today: How Leaders are Responding
Today’s academic medical center (AMC) leaders are reluctant jugglers. In today’s healthcare environment, there isn’t much choice. Expert juggler status ...

Education
Education Shouldn’t End at Licensure: Why Today’s Healthcare Training Model Falls Short
In the global healthcare workforce, there’s a common, yet deeply flawed, cultural assumption: once you’ve earned your degree, passed your ...

Professional Development
How Interactive Visuals And Clinical Reasoning Strengthen Healthcare Education
Images have always been valuable for teaching medicine. A 2018 study found that just two weeks of image-based e-learning can ...
Education
Different Medical Applications for Petri Dishes
Petri dishes play an important role in the medical industry and serve a wide range of applications—we’re exploring those applications in this guide.





